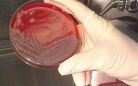

Находящийся в областной инфекционной больнице сын погибшего от заражения сибирской язвой жителя села Еркіндік Карагандинской области обвиняет врачей в халатности. По словам 23-летнего парня, отца можно было бы спасти, если бы он своевременно получил медицинскую помощь, передает корреспондент Today.kz.
Официальная информация, по словам Нуртiлеу, несколько отличается от того, что было на самом деле. "Пишут, что мы корову резали 18 июня, а в этот день мы были в Караганде с отцом, куда приехали сами на машине в больницу", - сказал он.
Как пояснил сын погибшего, увидев непонятные пятна, сельчане обратились за медпомощью по месту жительства, но местная медсестра направила их в районную больницу, оттуда жители села поехали в Караганду. 18 июня в городской клинической больнице в Майкудуке отца с сыном осмотрели в приемном покое и порекомендовали обратиться за помощью в областной кожно-венерологический диспансер, однако и там, по словам Нуртiлеу, зараженные опасной инфекцией не получили никакой помощи. Затем, как рассказал парень, они обратились в областной медцентр и только в больнице Агадыря у них заподозрили инфекционное заболевание.
"Он (отец - Прим. автора) был слабым и всю ночь лежал дома, болел. Утром 19 июня медсестра, увидев опухоли, сказала, что мы зря приехали из Караганды, надо было там оставаться в больнице. На своей машине в сопровождении медсестры мы доехали до агадырской больницы, где врачи оказались нормальные и сразу увидели симптомы сибирской язвы. Начали лечить, поставили систему, и в 21:00 мы выехали в Караганду. Отец был в сознании. Приехали в инфекционную больницу в 01:00, отца забрали в реанимацию, потому что он был в очень тяжелом состоянии. После привезли соседку моего дяди, которому принадлежала корова. Что было дальше, вы знаете. Мы пострадали из-за халатности медиков и непрофессионализма ветеринара", - сказал Нуртiлеу.
Между тем медики настаивают на том, что людям была оказана своевременная помощь. "Пострадавший обратился 18 июня в областную инфекционную больницу, однако он не говорил, что был контакт с больным животным, а жалобы были только на бытовую рану. Факт обращения в инфекционную больницу зафиксирован, медики их приняли, назначили антибиотики и сделали прививку", - заявил представитель управления здравоохранения.
Напомним, 22 июня врачи рассказали, как жители Карагандинской области заразились сибирской язвой. По словам руководителя Управления здравоохранения Карагандинской области Ержана Нурлыбаева, врачи поступили правильно. Поскольку пациент заявил, что травму получил в быту, никаких сомнений у докторов не было. Пациент был вакцинирован от возможных сопутствующих инфекционных заболеваний. Ему была назначена антибактериальная терапия и рекомендовано динамическое наблюдение у хирурга.
Руководитель облздрава пояснил обстоятельства заражения и погибшей от инфекции жительницы села. Женщине, по словам ее родственников, сутки не могли поставить верный диагноз. Основной причиной заражения этой женщины стало то, что она при приготовлении фарша из мяса заболевшего животного пробовала его на вкус.
Напомним, в селе Еркіндік Карагандинской области из-за сибирской язвы введен режим ЧС. В эпицентре заражения в радиусе 50 километров ограничен доступ автотранспорта, а также перемещение товаров животного происхождения, все ведущие в населенный пункт дороги перекрыты. В зоне ЧС объявлен карантин. Тела двоих скончавшихся похоронят под слоем извести. Между тем стало известно, что сибирскую язву подозревают у девятого госпитализированного в Караганде.